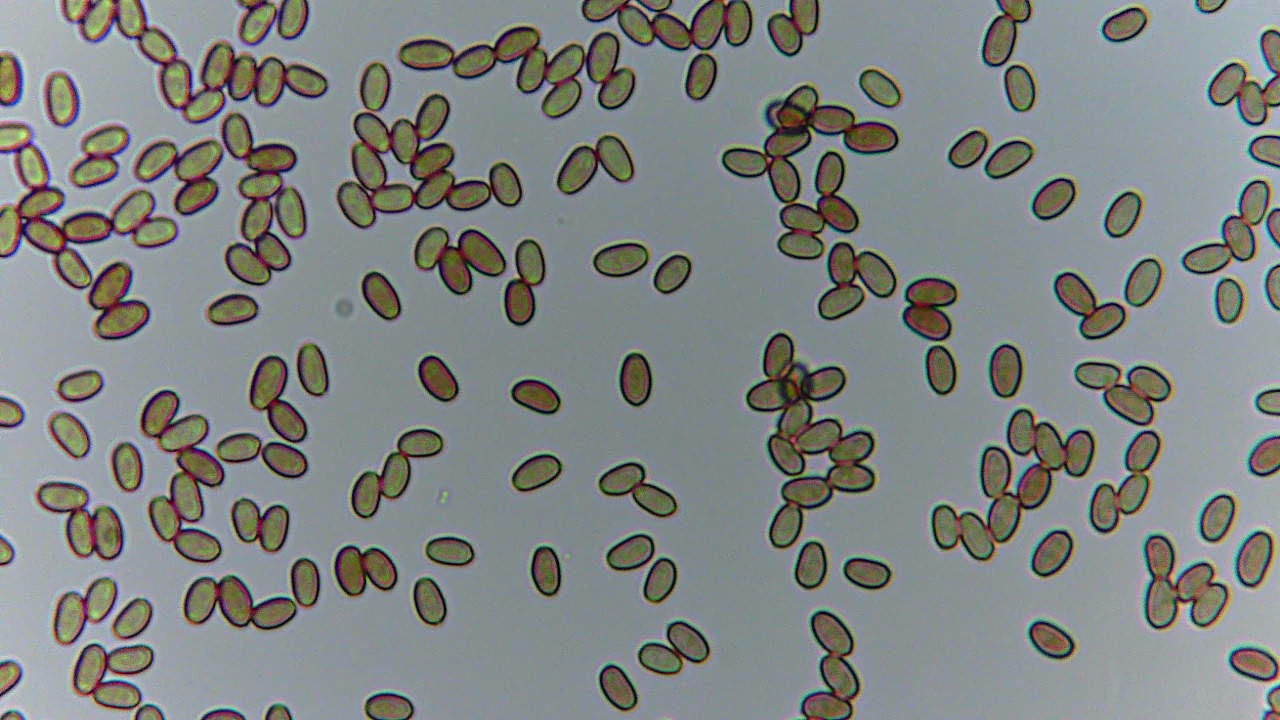

Unas cuantas del Domingo 03-11-24
Unas cuantas del Domingo 03-11-24
- javier
-
 Autor del tema
Autor del tema
- Fuera de línea
- Moderador
-

Menos
Más
- Mensajes: 5617
- Gracias recibidas: 4356
1 año 5 meses antes - 1 año 5 meses antes #110271
por javier
Unas cuantas del Domingo 03-11-24 Publicado por javier
Adjuntos:
Última Edición: 1 año 5 meses antes por javier.
El siguiente usuario dijo gracias: Josep Torres
Por favor, Identificarse para unirse a la conversación.
- Josep Torres
-

- Fuera de línea
- Moderador
-

Menos
Más
- Mensajes: 8746
- Gracias recibidas: 8379
1 año 5 meses antes #110274
por Josep Torres
Respuesta de Josep Torres sobre el tema Unas cuantas del Domingo 03-11-24
Gracias Javier por el aporte, solo añadir un par de apuntes, la Psathyrella candolleana como las demás Psathyrellas que no presentan pleurocistidios, a partir de 2020 se han reubicado dentro del nuevo género Candolleomyces, en este caso como Candolleomyces candolleanus, siendo esta la especie tipo, dejo el enlace:
www.speciesfungorum.org/Names/SynSpecies.asp?RecordID=832265
Luego la que me dices Lycogala epidendron, esta como tal no existe, en todo caso Lycogala epidendrum:
www.speciesfungorum.org/Names/SynSpecies.asp?RecordID=205910
Es que no soporto los nombre mal "escribidos"
Un abrazo
www.speciesfungorum.org/Names/SynSpecies.asp?RecordID=832265
Luego la que me dices Lycogala epidendron, esta como tal no existe, en todo caso Lycogala epidendrum:
www.speciesfungorum.org/Names/SynSpecies.asp?RecordID=205910
Es que no soporto los nombre mal "escribidos"
Un abrazo
El siguiente usuario dijo gracias: javier
Por favor, Identificarse para unirse a la conversación.
- javier
-
 Autor del tema
Autor del tema
- Fuera de línea
- Moderador
-

Menos
Más
- Mensajes: 5617
- Gracias recibidas: 4356
1 año 5 meses antes #110276
por javier
Respuesta de javier sobre el tema Unas cuantas del Domingo 03-11-24
Gracias Josep, ya está rectificado.
En el caso de la Psathyrella candolleana sigue siendo sinónimo de la nueva denominación que comentas, por lo tanto es válida y lo mas probable es que yo personalmente siga poniendo las que estoy acostumbrado y las que me costó aprender en su día, porque de lo contrario esto de la micología sería una auténtica locura con tantos sinónimos (en este caso 39) y no es de extrañar que en unos pocos años puedan superar los 50 sinónimos y así con el resto de especies.
No logro entender el gran empeño de algunos señores en prolongar cada muy poco tiempo, una y otra vez los nombres ya complicados de las setas (seguramente para que el libro o guía de setas que compres hoy, no tenga validez en pocos años) y repito que en mi caso no me voy a sumar al rebaño de estos pastores.
Pido por favor que se respete mi decisión de utilizar el sinónimo que me parezca y a quien no le guste o no lo entienda que simplemente ignore mi o mis temas de micología (otra cosa es que cometa alguna faltilla como ya me ha pasado anteriormente)
Species Fungorum - Species synonymy
salu2
En el caso de la Psathyrella candolleana sigue siendo sinónimo de la nueva denominación que comentas, por lo tanto es válida y lo mas probable es que yo personalmente siga poniendo las que estoy acostumbrado y las que me costó aprender en su día, porque de lo contrario esto de la micología sería una auténtica locura con tantos sinónimos (en este caso 39) y no es de extrañar que en unos pocos años puedan superar los 50 sinónimos y así con el resto de especies.
No logro entender el gran empeño de algunos señores en prolongar cada muy poco tiempo, una y otra vez los nombres ya complicados de las setas (seguramente para que el libro o guía de setas que compres hoy, no tenga validez en pocos años) y repito que en mi caso no me voy a sumar al rebaño de estos pastores.
Pido por favor que se respete mi decisión de utilizar el sinónimo que me parezca y a quien no le guste o no lo entienda que simplemente ignore mi o mis temas de micología (otra cosa es que cometa alguna faltilla como ya me ha pasado anteriormente)
Species Fungorum - Species synonymy
salu2
El siguiente usuario dijo gracias: Josep Torres
Por favor, Identificarse para unirse a la conversación.
- Josep Torres
-

- Fuera de línea
- Moderador
-

Menos
Más
- Mensajes: 8746
- Gracias recibidas: 8379
1 año 5 meses antes #110278
por Josep Torres
Respuesta de Josep Torres sobre el tema Unas cuantas del Domingo 03-11-24
Por supuesto Javier, puedes seguir llamándola como quieras, pero es que las nuevas denominaciones se hacen en base a datos microscópicos y en algunos casos a datos moleculares y sirven en muchas ocasiones para poner un poco de orden, como con la revisión de los Boletales de 2018 y de la que surgieron muchos otros géneros como Caloboletus, Hortiboletus, Rheubarbariboletus, Suillellus, Cianoboletus, Neoboletus, etc., etc, recientemente han silo los Cortinarius los que han sufrido una revisión y se han reordenado en géneros como Phlegmacium, Calonarius, Thaxterogaster, etc., etc, algo que personalmente considero necesario dentro del convulso género de los Cortinarius, creo que nos guste o no debemos acostumbrarnos a las nuevas denominaciones.
Un abrazo
Un abrazo
El siguiente usuario dijo gracias: javier
Por favor, Identificarse para unirse a la conversación.
Tiempo de carga de la página: 0.149 segundos

Foro de micología